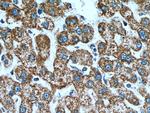
TOMM40 Antibody in Immunohistochemistry (Paraffin) (IHC (P))
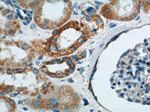
TOMM40 Antibody in Immunohistochemistry (Paraffin) (IHC (P))
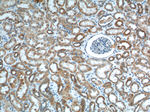
TOMM40 Antibody in Immunohistochemistry (Paraffin) (IHC (P))

Search
Proteintech
TOMM40 Polyclonal Antibody
{{$productOrderCtrl.translations['antibody.pdp.commerceCard.promotion.promotions']}}
{{$productOrderCtrl.translations['antibody.pdp.commerceCard.promotion.viewpromo']}}
{{$productOrderCtrl.translations['antibody.pdp.commerceCard.promotion.promocode']}}: {{promo.promoCode}} {{promo.promoTitle}} {{promo.promoDescription}}. {{$productOrderCtrl.translations['antibody.pdp.commerceCard.promotion.learnmore']}}
产品信息
18409-1-AP
种属反应
已发表种属
宿主/亚型
分类
类型
抗原
偶联物
形式
浓度
规格
纯化类型
保存液
内含物
保存条件
运输条件
产品详细信息
Immunogen sequence: MGNVLAASS PPAGPPPPPA PALVGLPPPP PSPPGFTLPP LGGSLGAGTS TSRSSERTPG AATASASGAA EDGACGCLPN PGTFEECHRK CKELFPIQME GVKLTVNKGL SNHFQVNHTV ALSTIGESNY HFGVTYVGTK QLSPTEAFPV LVGDMDNSGS LNAQVIHQLG PGLRSKMAIQ TQQSKFVNWQ VDGEYRGSDF TAAVTLGNPD VLVGSGILVA HYLQSITPCL ALGGELVYHR RPGEEGTVMS LAGKYTLNNW LATVTLGQAG MHATYYHKAS DQLQVGVEFE ASTRMQDTSV SFGYQLDLPK ANLLFKGSVD SNWIVGATLE KKLPPLPLTL ALGAFLNHRK NKFQCGFGLT IG (1-361 aa encoded by BC017224)
靶标信息
TOMM40 is the channel-forming subunit of the translocase of the mitochondrial outer membrane complex that is essential for protein import into mitochondria.
仅用于科研。不用于诊断过程。未经明确授权不得转售。
生物信息学
蛋白别名: haymaker protein; Mitochondrial import receptor subunit TOM40 homolog; mitochondrial outer membrane protein; mitochondrial outer membrane protein 35; Mitochondrial outer membrane protein of 35 kDa; Mitochondrial outer membrane protein of 38 kDa; MOM35; OM38; outer membrane protein 38 kDa; p38.5; PER EC1; Protein Haymaker; Translocase of outer membrane 40 kDa subunit homolog; translocase of outer mitochondrial membrane 40 homolog
基因别名: AW539759; C19orf1; D19S1177E; Mom35; OM38; PER-EC1; PEREC1; TOM40; Tom40a; TOMM40
UniProt ID: (Human) O96008, (Rat) Q75Q40, (Mouse) Q9QYA2
Entrez Gene ID: (Human) 10452, (Rat) 308416, (Mouse) 53333